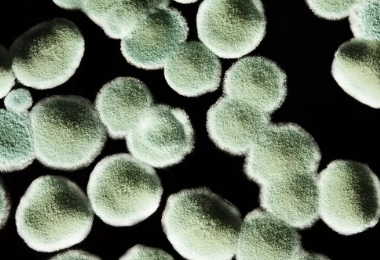
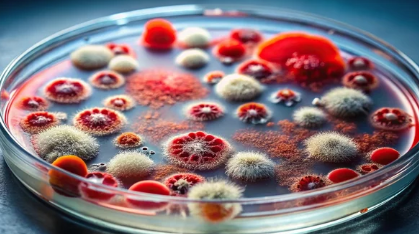
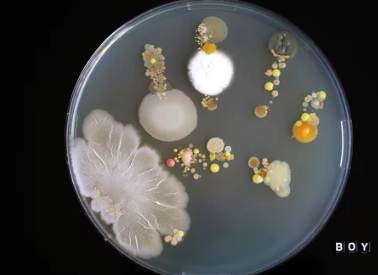

곰팡이균 감염 원인 치료방법 알아보기
- 카테고리 없음
- 2024. 9. 20. 03:00
곰팡이균 감염, 방치하면 큰일! 원인부터 치료까지 꼼꼼 가이드
혹시 피부에 붉은 반점이나 가려움증이 생겼나요? 발톱이 두꺼워지고 변색되었거나, 입안에 하얀 막이 생겼다면 '곰팡이균 감염'을 의심해 볼 필요가 있습니다. 곰팡이균 감염은 흔한 질환이지만, 방치하면 피부 손상, 탈모, 심지어 전신 감염까지 이어질 수 있습니다. 오늘은 곰팡이균 감염의 원인과 증상, 그리고 효과적인 치료 및 예방법까지 자세히 알아보고 건강한 피부와 몸을 지키는 데 도움이 되는 정보를 함께 나누겠습니다.
1. 곰팡이균 감염, 왜 발생할까? 다양한 원인과 감염 경로



곰팡이균은 우리 주변 어디에나 존재하며, 피부, 손발톱, 머리카락, 점막 등 다양한 부위에 감염을 일으킬 수 있습니다. 곰팡이균 감염은 곰팡이가 피부나 점막에 침투하여 증식하면서 발생하며, 습하고 따뜻한 환경, 면역력 저하, 상처 등이 감염 위험을 높입니다.
- 습하고 따뜻한 환경: 곰팡이는 습하고 따뜻한 환경에서 잘 번식합니다. 땀을 많이 흘리거나 습한 옷을 오래 입는 경우, 샤워 후 물기를 제대로 닦지 않는 경우, 수영장이나 공중목욕탕 이용 후 곰팡이균에 감염되기 쉽습니다.
- 면역력 저하: 면역 체계가 약해지면 곰팡이균에 대한 저항력이 떨어져 감염되기 쉽습니다. 당뇨병, HIV 감염, 암 환자, 장기 이식 환자 등 면역력이 약한 사람들은 특히 주의해야 합니다.
- 피부 손상: 피부에 상처가 있거나 습진, 건선 등 피부 질환이 있는 경우 곰팡이균이 쉽게 침투하여 감염을 일으킬 수 있습니다.
- 공동 사용: 수건, 빗, 신발 등 개인 용품을 다른 사람과 공동으로 사용하면 곰팡이균 감염 위험이 높아집니다.
- 항생제 장기 복용: 항생제 장기 복용은 장내 유익균을 감소시키고 곰팡이균 증식을 촉진하여 감염 위험을 높일 수 있습니다.
- 꽉 끼는 옷 & 신발: 통풍이 잘 되지 않는 꽉 끼는 옷이나 신발은 습한 환경을 조성하여 곰팡이균 증식을 촉진합니다.
2. 곰팡이균 감염, 어떤 증상이 나타날까? 가려움부터 통증까지 다양한 증상

곰팡이균 감염은 감염 부위에 따라 다양한 증상을 유발할 수 있습니다.
- 피부 곰팡이증 (무좀, 완선, 어루러기 등):
- 가려움증: 가장 흔한 증상으로, 참을 수 없는 가려움을 동반합니다.
- 발진: 붉은 반점, 물집, 구진, 농포 등 다양한 형태의 발진이 나타날 수 있습니다.
- 각질 & 벗겨짐: 피부가 건조해지고 각질이 일어나거나 벗겨질 수 있습니다.
- 악취: 발 냄새, 땀 냄새 등 불쾌한 냄새가 날 수 있습니다.
- 손발톱 곰팡이증:
- 손발톱 변색: 손발톱이 하얗게 또는 노랗게 변색됩니다.
- 손발톱 두꺼워짐: 손발톱이 두꺼워지고 부서지기 쉽습니다.
- 손발톱 변형: 손발톱 모양이 변형되거나 들뜨는 경우도 있습니다.
- 통증: 심한 경우 손발톱 주변에 통증이나 염증이 발생할 수 있습니다.
- 두피 곰팡이증:
- 비듬: 두피에 하얀 각질이 많이 생기고 가려움증을 동반합니다.
- 탈모: 심한 경우 탈모가 발생할 수 있습니다.
- 염증 & 농포: 두피에 염증이나 농포가 생길 수 있습니다.
- 구강 칸디다증:
- 입안 하얀 막: 혀, 입천장, 볼 안쪽 등에 하얀 막이 생깁니다.
- 구강 작열감: 입안이 화끈거리거나 따끔거리는 느낌이 듭니다.
- 미각 변화: 맛을 제대로 느끼지 못하거나 맛이 변하는 느낌이 들 수 있습니다.
- 전신 곰팡이증:
- 발열, 오한, 피로감 등 전신 증상이 나타날 수 있습니다.
- 면역력이 약한 사람에게 발생하기 쉬우며, 심각한 합병증을 유발할 수 있습니다.
3. 곰팡이균 감염, 방치하면 위험하다! 🚨 합병증과 전신 감염 주의

곰팡이균 감염은 초기에 치료하지 않고 방치하면 증상이 악화되고 다른 부위로 퍼지거나 전신 감염으로 이어질 수 있습니다.
- 피부 손상 & 흉터: 곰팡이균 감염은 피부 손상과 흉터를 남길 수 있습니다. 특히 긁거나 뜯는 행위는 흉터를 악화시킬 수 있으므로 주의해야 합니다.
- 탈모: 두피 곰팡이증을 방치하면 영구적인 탈모로 이어질 수 있습니다.
- 2차 세균 감염: 곰팡이균 감염 부위에 세균 감염이 추가로 발생하여 증상을 악화시킬 수 있습니다.
- 전신 감염: 면역력이 약한 사람의 경우 곰팡이균이 혈액을 통해 전신으로 퍼져 폐, 뇌, 심장 등 주요 장기에 감염을 일으킬 수 있습니다. 전신 곰팡이증은 치명적인 합병증을 유발할 수 있으므로 조기 진단과 치료가 매우 중요합니다.
4. 곰팡이균 감염, 치료 방법은? 항진균제와 생활 습관 개선



곰팡이균 감염 치료는 항진균제를 사용하여 곰팡이를 제거하고 증상을 완화하는 데 중점을 둡니다. 치료 기간은 감염 부위와 심각도에 따라 다르며, 의사의 지시에 따라 꾸준히 치료받는 것이 중요합니다.
- 항진균제:
- 국소 항진균제: 연고, 크림, 젤, 스프레이 등 다양한 형태로 제공되며, 피부 곰팡이증, 손발톱 곰팡이증 치료에 사용됩니다.
- 경구 항진균제: 먹는 약으로, 심한 곰팡이 감염이나 손발톱 곰팡이증 치료에 사용됩니다.
- 샴푸: 두피 곰팡이증 치료를 위해 항진균 성분이 함유된 샴푸를 사용할 수 있습니다.
- 구강청결제: 구강 칸디다증 치료를 위해 항진균 성분이 함유된 구강청결제를 사용할 수 있습니다.
- 생활 습관 개선:
- 청결 유지: 감염 부위를 깨끗하고 건조하게 유지합니다. 샤워 후 물기를 꼼꼼하게 닦고, 땀을 많이 흘린 경우 옷을 갈아입습니다.
- 통풍: 통풍이 잘 되는 옷과 신발을 착용하고, 꽉 끼는 옷이나 신발은 피합니다.
- 개인 용품: 수건, 빗, 신발 등 개인 용품은 다른 사람과 공유하지 않습니다.
- 면역력 강화: 균형 잡힌 식단, 규칙적인 운동, 충분한 수면 등 건강한생활 습관을 통해 면역력을 강화하고 곰팡이균 감염을 예방하세요.
5. 검색 엔진 최적화를 위한 추가 정보

- 메타 설명: 곰팡이균 감염, 방치하면 위험합니다! 피부, 손발톱, 두피, 입안 등 다양한 부위에 발생하는 곰팡이균 감염의 원인, 증상, 치료 및 예방법을 자세히 알아보세요.
- 키워드: 곰팡이균 감염, 무좀, 완선, 어루러기, 손발톱 곰팡이증, 두피 곰팡이증, 구강 칸디다증, 전신 곰팡이증, 항진균제, 피부 질환, 면역력 저하, 습진, 건선, 당뇨병, HIV 감염
- 헤더 태그: 적절한 헤더 태그(H1, H2, H3 등)를 사용하여 글의 구조를 명확하게 하고 가독성을 높입니다.
- 이미지 및 동영상: 곰팡이균 감염 부위 이미지, 항진균제 종류, 건강한 생활 습관 관련 이미지 등을 추가하여 글의 시각적인 효과를 높이고 정보 전달력을 향상시킵니다.
- 내부 링크 및 외부 링크: 곰팡이균 감염 관련 정보 페이지, 피부 질환 관련 정보 페이지, 건강 관련 기관 웹사이트 등 관련성 높은 내부 링크와 외부 링크를 추가하여 정보의 신뢰성을 높이고 검색 엔진 순위를 향상시킵니다.
- 소셜 미디어 공유: 소셜 미디어 공유 버튼을 추가하여 콘텐츠 확산을 유도합니다.